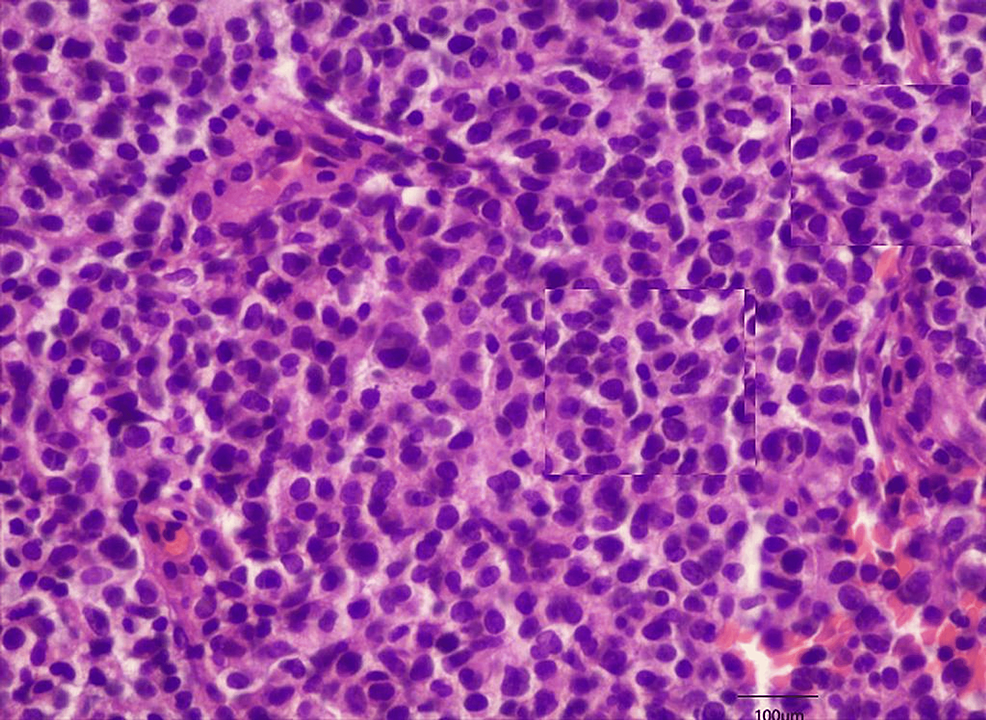
症状と兆候

メルケル細胞癌は、まれで悪性度の高いタイプの皮膚癌です。
メルケル細胞癌 (MCC) は、これらの皮膚癌細胞が皮膚の最上層に位置するメルケル細胞に似ていることからその名前が付けられました。
メルケル細胞は指先、唇、顔に最も集中していますが、MCC 細胞は頭、首、その他日光に最も多くさらされた領域で発生する可能性が最も高くなります。
以下では、MCC の原因、症状、予防方法について学びます。診断と治療法についても説明します。
癌腫は、内臓を覆うまたは内側を覆う皮膚または組織で発生する癌の一種です。がんは、細胞がランダムに分裂し、制御不能に成長し始めると発生します。この細胞の増殖は最終的に癌性腫瘍と呼ばれる塊を形成します。
MCCは皮膚がんの一種で、その細胞はメルケル細胞に似ています。これらは皮膚の神経終末の近くに位置しており、軽い接触の感覚をもたらすのに役立ちます。また、圧力や質感などの詳細に関する情報を皮膚から脳に伝えます。
メルケル細胞は、神経およびホルモン産生細胞と共通の特徴を持っています。その結果、それらは神経内分泌細胞として分類され、MCC は皮膚の神経内分泌癌と呼ばれることもあります。 MCCの別名は小柱癌です。
MCCは非常に珍しいです。 2018年には米国で約2,000人がこの診断を受けた。しかし、その普及率は高まっているようです。
2000 年から 2013 年の間に、国内で MCC と診断された人の数は 95% 増加しました。専門家は、2025 年までに米国で毎年約 3,250 人の新たな MCC 症例が診断されると推定しています。
有病率の増加は、米国における高齢者人口の増加に関係していると考えられます。MCC のほぼ全員が 50 歳以上です。
MCCは、時間の経過とともに最も日光にさらされる部位である頭と首に発症する傾向があります。危険因子には次のようなものがあります。
- 紫外線への曝露:紫外線への過剰または長時間の曝露は、皮膚細胞の増殖を制御する遺伝子の DNA に損傷を与え、皮膚がんを引き起こす可能性があります。暴露は通常、保護なしで太陽の下で時間を過ごすことによって起こりますが、日焼けベッドや乾癬の光線療法も影響している可能性があります。
- 高齢者: MCC は 50 歳未満の人ではまれであり、米国ではこのがんに罹患している 10 人中 8 人が 70 歳以上です。これは、時間の経過とともに皮膚のダメージが増加し、年齢とともに免疫システムが低下するためである可能性があります。
- 免疫システムの弱体化:健康な免疫システムは、がん細胞の破壊に役立ちます。
- 男性の性別:米国では男性は女性の 2 倍、MCC を発症する可能性が高いと考えられます。
- 肌の色が明るい:このタイプの肌の人は、MCC のリスクが高くなります。
- メルケル細胞ポリオーマウイルス感染症: MCC 患者の約 10 人中 8 人が癌細胞内にこのウイルスを持っています。多くの人が、ある時点、多くは小児期にウイルスに感染しますが、それが MCC の原因となることはほとんどありません。
MCC は通常、次の内容に基づいて開発します。
- 顔
- ネック
- 腕
- 脚
まれに、食道や鼻に発生することもありますが、長期間にわたって大量の紫外線にさらされた領域に影響を与える傾向があります。
MCC の症状は、より一般的な他の種類の皮膚がんの症状と似ている場合があります。ただし、MCC腫瘍には次のような特徴があります。
- 硬くて盛り上がる傾向がある
- ピンク、赤、紫かもしれません
- 通常は痛みはありませんが、開いて痛みを伴い、出血性のただれや潰瘍が生じる場合があります。
- 急速に成長する
- 虫刺され、 嚢胞、またはものもらいに似ている場合があります
- 広がり、皮膚の下に新しい小さなしこりを形成することがあります
- 周囲のリンパ節が腫れる可能性がある
- 平均直径は1.7センチメートルで、10セント硬貨とほぼ同じです。
- ドーム状になることもある
- 悪性黒色腫腫瘍のように、暗色になることはほとんどありません。
- 扁平上皮癌の腫瘍のように、鱗状になることはほとんどありません。
MCC を診断するには、皮膚疾患、がん、またはその両方を専門とする医師が次のことを行います。
- 成長部分の周囲の皮膚を調べ、近くのリンパ節を触ってください。
- 詳細な検査のために、影響を受けた皮膚細胞または腫瘍を除去します。
- これにより MCC の存在が確認された場合、センチネルリンパ節生検 (SLNB) が行われます。これには、非常に細い針を使用して周囲のリンパ節から微量のサンプルを採取することが含まれます。
- がんの範囲をさらに詳しく知るために、医師は PET スキャンや MRI スキャン、その他の検査を行います。
MCCは急速に増殖し広がる傾向があるため、治療は困難です。最適なアプローチは、次のような要因によって異なります。
- その人の年齢
- 彼らの一般的な健康状態
- 腫瘍の位置
- がんの段階または範囲
- 治療の潜在的な副作用
- それぞれのアプローチががんを根絶するか、大幅な改善につながる可能性
段階別の治療法の選択肢
さまざまな考慮事項が最適な治療法を決定するのに役立ちますが、多くの場合、MCC の段階が最も重要な要素となります。
以下では、段階と推奨される治療法について学びます。
明らかな広がりのない MCC
がんが転移しているかどうかを確認するために SLNB を受けた後、ほとんどの人は広範囲の局所切除を受けます。この手順では、皮膚から癌細胞を除去します。
MCCが顔やその他の敏感な領域にある場合は、代わりにモース顕微鏡手術を受けることができ、これによりより健康な皮膚を維持することができます。
一部の人々は、特に周囲のリンパ節を標的とした放射線療法も、または交互に受けることがあります。
スプレッド付きクライアント センター(MCC)
これを治すのは非常に難しい場合があります。次のものが必要になる場合があります。
- 影響を受けた細胞を除去する手術
- 放射線治療
- 化学療法
- 免疫療法薬、ペムブロリズマブ ( キイトルーダ) やアベルマブ (バヴェンシオ) など
定期的なクライアント センター
MCCが再発した場合、医師は多くの場合、次の組み合わせを推奨します。
- 影響を受けた組織をさらに除去する手術(おそらく周囲のリンパ節も含めて)
- 放射線治療
- 化学療法
- キイトルーダやバベンシオなどの免疫療法薬
再発性 MCC は、特に別の部位に再発した場合、治療が非常に困難になることがあります。このような場合、医師は病気を治すことではなく、症状を軽減することに重点を置く傾向があります。
以下のような MCC の補完療法を試みる人もいます。
- 自然療法医学
- 食事の変更
- 免疫力を高めるサプリメント
MCC 患者の見通しは、がんの段階、治療アプローチ、年齢や免疫系の強さなどの要因によって異なります。
転移していないMCC患者の約78%は、診断後さらに5年間生存します。この推定値は 5 年生存率と呼ばれます。
また、このタイプのがんの患者の多くが再発を経験し、多くの場合、最初の診断から 2 ~ 3 年以内に再発を経験することも注目に値します。
年齢や男性の性別など、MCC の危険因子の多くは予防が困難または不可能です。ただし、次のことに役立ちます。
- 紫外線への曝露を制限します。
- 屋外にいるときは日陰にいてください。
- 屋外では帽子など体を覆う服装を着用してください。
- 日焼け止めとサングラスを着用してください。
- 日光灯や日焼けベッドは避けてください。
- 毎月皮膚を検査し、気になる変化についてはできるだけ早く医師に相談してください。
- 健康的でバランスの取れた食事をとりましょう。
- 定期的に運動しましょう。
- 水分補給をしてください。
- 十分な休息をとりましょう。
- 性行為中は保護具を使用してください。
- 静脈内薬は使用しないでください。
- 受動喫煙を避け、該当する場合は禁煙してください。
急速に拡大または拡大する皮膚の痛みや成長がある人は、できるだけ早く医師に連絡する必要があります。 MCC の治療を早期に受けることにより、合併症のリスクが軽減され、見通しが良くなります。
MCCの治療を求める場合は、必ずこの病気の経験がある専門医を見つけてください。この医師は、皮膚の状態の診断を専門とする皮膚病理学者とも連携する必要があります。
メルケル細胞癌:原因、症状、治療・関連動画
参考文献一覧
- https://www.cancer.org/cancer/merkel-cell-skin-cancer/detection-diagnosis-staging/survival-rates.html
- http://www.medicalnewstoday.com/articles/146309
- http://www.medicalnewstoday.com/articles/158401
- https://merkelcell.org/about-mcc/symptoms-and-Appearance-of-merkel-cell-carcinoma/
- https://merkelcell.org/treatment/mohs-micrographic-surgery/
- https://www.cancer.org/cancer/merkel-cell-skin-cancer/causes-risks-prevention/risk-factors.html
- https://www.skincancer.org/skin-cancer-information/merkel-cell-carcinoma/
- https://merkelcell.org/treatment/complementary-and-alternative-therapies/
- https://www.aad.org/public/diseases/skin-cancer/types/common/merkel-cell/symptoms
- https://www.cancer.org/cancer/merkel-cell-skin-cancer/treating/common-treatments-by-extent.html
- https://www.aad.org/public/diseases/skin-cancer/types/common/merkel-cell
- http://www.medicalnewstoday.com/articles/154322